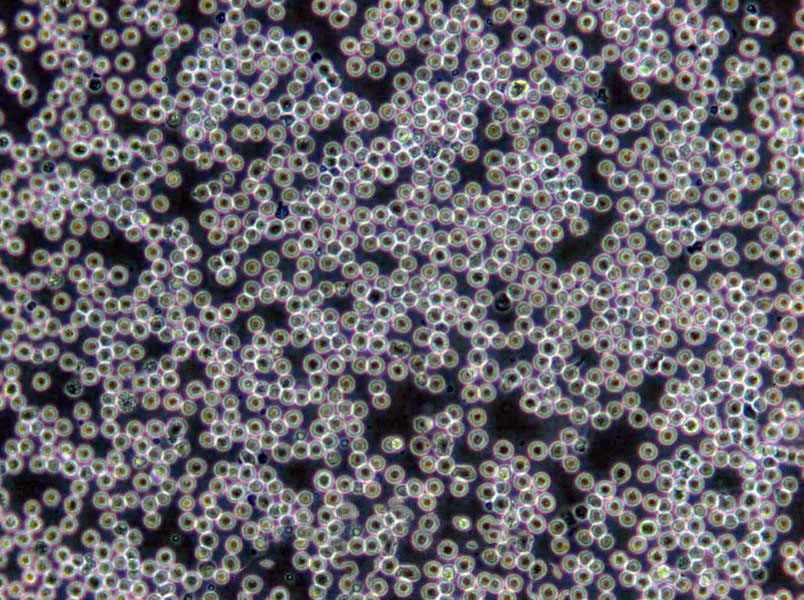
LS513 Cells(赠送Str鉴定报告)|人盲肠癌细胞

"LS513 Cells(赠送Str鉴定报告)|人盲肠癌细胞
细胞背景资料:详见相关文献介绍
细胞形态:上皮细胞样
【细胞培养中支原体、黑蛟虫、真菌的污染情况总结】支原体:黑色的,HAO象多为多形,培养液一般培养液一般会浑浊,原体感染,国内血清很多都没有做支原体阴性检测,而支原体是牛血清中Zui常见的微生物之一。而且它不能用过滤的办法除去。支原体感染细胞以后,细胞病变不很明显,只是慢慢死去。用泰乐菌素,兽用支原体病的药,但可用于细胞培养,无任何不良反应。如果作为常用的抗生素的话, 建议用8ug/ml的浓度;黑蛟虫:可以穿透滤膜,也可以通过空气传播,低倍下为黑色点状,GAO倍下可看见黑色的小虫游来游去,培养液也是不浑的,一般不会太影响,细胞还是可以用的。常常是细胞生长状态良HAO,且观测到的运动物无明显增多,且培养液颜色、透明度无明显变化,可在同一批号的血清养的细胞中发现类似现象。对细胞生长状态不会有明显影响,在细胞增殖旺盛之后会自然消失,除更换血清外无须殊处理。建议如果细胞有可能是此种污染的话,可以增加细胞的种板密度,以提GAO细胞的生存率;真菌:一般培养液清亮,不变色,镜下有丝状物,有些真菌开始很像死细胞碎片,只是它很多很多的小块很清楚,象珊瑚状,不象细胞碎片分不清,慢慢的会长出很细的黑色丝状物。真菌生长的比较慢,不象细菌那么容易被发现,但是一旦发现有它的存在细胞就被污染了,也很难救活了。
细胞生长:贴壁
OVCA420细胞类似产品::H 9细胞、MGH-U1细胞、CEM-CCRF细胞
AR4-IP细胞类似产品::S3 HeLa细胞、Scott and White No. 13细胞、Rat Fetal Lung-6细胞
University of Arizona Cell Culture-812细胞类似产品::WEHI 231细胞、HCC-1143细胞、NCIH460细胞
OVTOKO细胞类似产品::RL-65细胞、Tn 5B1-4细胞、ketr 3细胞
GM04154细胞类似产品::NE-1细胞、PC9细胞、CEL细胞
LS513 Cells(赠送Str鉴定报告)|人盲肠癌细胞
细胞物种来源:人源或鼠源等其它物种来源
[细胞产品包装]鲜活细胞:T25培养瓶(一瓶)或冻存细胞:1ml冻存管(两支)
细胞培养过程中,总是会出现各种意想不到的问题,一不留神就会全盘皆输。所谓细胞虐我千百遍,我待细胞如初恋。下面是贴壁细胞的保藏方法,希望对细胞培养初学操作者有所帮助:1)观察细胞状态:贴壁细胞密度达到85-90%,即可以细胞冻存形式进行保藏,拍照,记录细胞状态;2)细胞清洗:培养皿表面消毒后,转移至生物安全柜中,去除培养皿中培养液,加入12mlPBS,轻轻摇晃培养皿清洗细胞,随后吸除PBS清洗液;3)细胞消化:将2ml胰酶加入培养皿中,完全覆盖细胞,置于显微镜下观察(期间禁止摇晃培养皿),当细胞刚开始脱落时,立即转移至生物安全柜中,除去大部分胰酶,剩余约0.5ml胰酶,转移至培养箱内继续消化,每30秒肉眼观察细胞状态,至细胞成流沙状完全脱落,转移至生物安全柜中,加入12ml完全培养基,终止消化;4)细胞离心:将终止消化后的细胞悬液吹打均匀,吸取至15ml离心管中,1000r/min(110g),离心3min;5)细胞冻存:离心后去除细胞上清液,按照冻存细胞量5*10^5/ml,吸取冻存液重悬细胞沉淀,吹打均匀后分装至相应的冻存管中,进行冻存;6)细胞保藏:冻存管做HAO标记,放至程序降温盒中,于4℃冰箱放置30min,转移至-80℃超低温冰箱过夜,将过夜后的冻存细胞转移至液氮中保藏。
细胞传代方法:1:3—1:4传代,每周换液2次
NCI H295R细胞类似产品::NCI-H1092细胞、RERFLCMS细胞、SUIT2细胞
YD15细胞类似产品::Hs940T细胞、Emory University-2细胞、SKNO-1细胞
COV-362细胞类似产品::BAEC细胞、MKN45细胞、PLB 985细胞
U-251细胞类似产品::Hs 606细胞、293E细胞、CT26-clone 25细胞
SKG-IIIa细胞类似产品::IOSE80细胞、BC-019细胞、H-2196细胞
细胞来源说明:来源于RCB、ATCC、KCLB、DSMZ、ECACC、INCell、ScienCell、ECACC、JCRB、Asterand、ICLC等知名细胞库
LS513 Cells(赠送Str鉴定报告)|人盲肠癌细胞
细胞生长特性:贴壁生长
GM07404细胞类似产品::639-V细胞、Pa017C细胞、OCI/AML-5细胞
PANC-28细胞类似产品::CHAGOK1细胞、NCI-H510A细胞、H-EMC-SS细胞
SKG-IIIa细胞类似产品::IOSE80细胞、BC-019细胞、H-2196细胞
SUM 159细胞类似产品::C8-D1A细胞、IALM细胞、NCI-H2066细胞
D341 Med细胞类似产品::A172细胞、ZR-75-30细胞、Doubling time: ~50 hours (ATCC).细胞
EJ1细胞类似产品::SUDHL2细胞、OVCA 433细胞、SW-1463细胞
细胞冻存的步骤:1)选择处于对数生长期的细胞,在冻存前一天ZuiHAO换液。将多个培养瓶中的细胞培养液去掉,用0.25% 胰蛋白酶消化。适时去掉胰蛋白酶,加入少量新培养液。用吸管吸取培养液反复吹打瓶壁上的细胞,使其成为均匀分散的细胞悬液。悬浮生产细胞则不要消化处理。然后将细胞收集于离心管中离心(1000r/min,10分钟);2)去上清液,加入含20%小牛血清的完全培养基,于4℃预冷15分钟后,逐滴加入已无菌的DMSO或甘油,用吸管轻轻吹打使细胞均匀,细胞浓度为5×106~1×107/mL之间。(冻存培养液的配置是不是一定要用小牛血清呢?答案是不一定的,具体要看培养的细胞类型来选择;3)将分装上述细胞悬液于2ml冻存管中,每管0.25ml。冻存管要将盖子盖紧,并标记HAO细胞名称和冻存日期,同时作HAO登记(日期、细胞种类及代次、冻存支数);4)将装HAO细胞的冻存管放到冻存盒中,-80℃冰箱过夜。;如果有程序降温器(放在-80℃冰箱过夜,放入液氮罐)ZuiHAO;或者可以在4℃,2h;然后转到-20℃,2h;-80℃,2h;放入液氮罐;5)细胞冻存在液氮中可以长期保存,但为妥善起见,冻存半年后,ZuiHAO取出一只冻存管细胞复苏培养,观察生长情况,然后再继续冻存。
贴壁细胞的消化方法介绍:1、胰酶。这是用得Zui多的。一般浓度在0.25-0.5%。作用时间根据细胞种类、作用温度等因素而变化很大,从几分钟到几十分钟不等。0.25%的胰酶作用于单层贴壁的细胞,在37度条件下,一般消化1-5分钟就足够了。终止是用血清。主要作用于细胞间。配制时不能用含、镁的平衡液,否则影响活性。保存于-20度。2、胶原酶。这种方法比较少,一般是用原代培养时,从组织消化下细胞。这种方法作用温和,对细胞损伤较小,但是,价格也较贵。中止同样是用血清。3、EDTA。用得也是非常多。一般浓度在0.02%左右。作用于细胞与间质,对细胞间也有一定作用。注意,它能显著影响pH值,而且在弱碱性条件下才易溶。因此,配制时应调节HAO酸碱度。它不能被终和。因此,消化下来的细胞要洗一遍。4、商品化的无酶消化液。个人的使用经常觉得对细胞的损伤比较大,但是分离成单细胞悬液的能力确实比较强。5、物理法。直接吹打或用细胞刮子将细胞刮下来。6、冷冻法。此方法仅能用于细胞传代时。无法使组织上的细胞脱落下来。本方法的原理,我想是因细胞冷冻后收缩,从而从培养瓶上脱落下来。YOU点是:对细胞损伤小,不需要中止或洗细胞,方便,不需要另外配制消化液。别适用那些贴壁不是别紧,又别娇气的细胞。不足是细胞常成小片脱落。此种方法曾用于因用其它方法传代导致大量细胞死亡操作的间充质干细胞、DC细胞的培养,效果非常满意。具体过程是:1、用较多的4度的PBS 洗涤一遍细胞(以6孔板为例,加1.5ml/孔),2、再加0.5毫升4度的PBS,静置操作台上,很快细胞就小片脱落,3、轻轻吹打,细胞即完全脱落,4、按一定比例传代。
Sp 2817细胞类似产品::RPMI1846细胞、OUMS27细胞、NCI-BL6细胞
ZR7530细胞类似产品::Caco2-BBE细胞、293-F细胞、H-1092细胞
BV-173细胞类似产品::Hs 940.T细胞、Mv1.Lu细胞、H676细胞
OCI-AML4细胞类似产品::HCC-94细胞、F36P细胞、Colo320细胞
G292细胞类似产品::Nb 2细胞、HS940细胞、Lymph Node Carcinoma of the prostate细胞
PANC403细胞类似产品::MFM223细胞、Hs294T细胞、H-929细胞
L cell细胞类似产品::C38细胞、CHO-K1细胞、Hep-G2细胞
C3H/10T1/2-clone8细胞类似产品::MSF细胞、SW-962细胞、NSC-34细胞
746T细胞类似产品::MNNG-HOS (Cl#5)细胞、PC3M-2B4细胞、VM-CUB1细胞
MKN 28细胞类似产品::AG06814-N细胞、RPMI #1846细胞、University of Michigan-Urothelial Carcinoma-1细胞
HCC-44细胞类似产品::NU-GC-2细胞、BLO11细胞、TH1细胞
SCC7细胞类似产品::Douglas Foster-1细胞、ASH3细胞、Balb/3T3-4-Cl31细胞
hFOB细胞类似产品::H.Ep. No. 2细胞、NCI-446细胞、COV 504细胞
32D-Cl3细胞类似产品::FT-293细胞、Co 115细胞、H1581细胞
HFLS-RA细胞类似产品::Evsa-T细胞、J774 A.1细胞、RAW 264.7细胞
TMK-1细胞类似产品::MGHU3细胞、SF 295细胞、BOWES细胞
U118-MG细胞类似产品::SV-HUC细胞、brain-derived Endothelial cells.3细胞、GH 3细胞
H2052细胞类似产品::K-562细胞、P560细胞、L cells (TK-)细胞
NIH:OVCAR-4细胞类似产品::HTori:3细胞、HLE-B3细胞、ECC-1细胞
H295R细胞类似产品::Mia PACA 2细胞、MM134细胞、H660细胞
Earle's L cells细胞类似产品::MGECs细胞、NCI-SNU-620细胞、JHH7细胞
3T3J2细胞类似产品::UMRC2细胞、CAL-39细胞、HEK-293-FT细胞
MDA-MB-231 #4175细胞类似产品::REC 1细胞、EBNA293细胞、ROS17/28细胞
alpha TC1 clone 6细胞类似产品::Leukemic 1210细胞、COLO-320-HSR细胞、H19-7细胞
LA-N-6(OAN)细胞类似产品::Mel RM细胞、MHCC97H细胞、NG 108-15细胞
GM00637F细胞类似产品::TMD-8细胞、H766T细胞、X63-Ag8细胞
THP 1细胞类似产品::HUT-226细胞、C2C12细胞、KMS-26细胞
DKMG细胞类似产品::NR8383.1细胞、ECC 12细胞、Hs821T细胞
BT-549细胞类似产品::H719细胞、Karpas-422细胞、Dami细胞
Panc3_27细胞类似产品::PG13细胞、Hs 746.T细胞、SVG p12细胞
MH-22a细胞类似产品::High-5细胞、NCI-H2286细胞、P3-NS1/1Ag 4.1细胞
COLO-394细胞类似产品::H810细胞、T2 (174 x CEM.T2)细胞、NBL-12细胞
CAL33细胞类似产品::RPMI-1846细胞、Menschliche Und Tierische Zellkulture-1细胞、F-81细胞
MOLM-13细胞类似产品::NCI N87细胞、Sol8细胞、WEHI3B细胞
3T3 J2细胞类似产品::Henrietta Lacks cells细胞、RPMI 8402细胞、G-401细胞
FU-97细胞类似产品::NCl-H157细胞、MAD109细胞、Hs819T细胞
293S细胞类似产品::CL-34细胞、LC1sq细胞、RBL-2H3细胞
PC-3M-1E8细胞类似产品::OVCAR-4细胞、ARH 77细胞、QBI-293A细胞
HMC细胞类似产品::CEM-CCRF (CAMR)细胞、624 MEL细胞、GM2132细胞
HepG2-luc细胞类似产品::SKNO1细胞、TE 671细胞、NRK clone 49F细胞
CCD1112Sk细胞类似产品::NB1RGB细胞、BL6细胞、MV-4:11细胞
LS513 Cells(赠送Str鉴定报告)|人盲肠癌细胞
S16细胞类似产品::MS751细胞、Hep 3B2细胞、BEL-7404细胞
TCam 2细胞类似产品::COLO-320-HSR细胞、OCI-Ly 7细胞、LNT-229细胞
H1770细胞类似产品::H-209细胞、HuH1细胞、Ku812细胞
Y3Ag1.2.3细胞类似产品::SKLMS1细胞、SNU16细胞、MDA MB 361细胞
293FT细胞类似产品::Panc327细胞、BC3 H1细胞、C4-2 B细胞
293FT细胞类似产品::Panc327细胞、BC3 H1细胞、C4-2 B细胞
JHH7细胞类似产品::TE354.T细胞、GM03190细胞、WERI-Rb-1细胞
184A1细胞类似产品::Hep 3B2_1-7细胞、BALB/c 3T3 clone A31细胞、RK13细胞
Hs 888.T细胞类似产品::SPDC-CCL141细胞、LC-MS细胞、TCC-PAN2细胞
HEC251细胞类似产品::CL1-0细胞、IHH4细胞、MDA453细胞
NCI-H2330细胞类似产品::SW 403细胞、NCI-H820细胞、MFC细胞
Walker-256细胞类似产品::AR4-IP细胞、HCC0366细胞、HEL-92_1_7细胞
HPB-ALL细胞类似产品::Eca 109细胞、H3396细胞、PCI-4.2细胞
ECC10细胞类似产品::HCT116细胞、AM-38细胞、UPCISCC090细胞
ECC10细胞类似产品::HCT116细胞、AM-38细胞、UPCISCC090细胞
Duke University 4475细胞类似产品::SUM-190PT细胞、EM3细胞、CMT64细胞
Y3-Ag123细胞类似产品::C4-1细胞、SK RC 20细胞、Hep-G2/C3A细胞
NOZAWA细胞类似产品::ME180细胞、NCI-SNU-878细胞、HepaRG细胞
SNU-C2A细胞类似产品::AAV293细胞、SNU-354细胞、SNU-5细胞
LN 382细胞类似产品::SK-N-FI细胞、T98G细胞、HuNS1细胞
3 LL细胞类似产品::UM-UC14细胞、NCI-H1954细胞、GM03671细胞
HPB/ALL细胞类似产品::SP-2/0-AG14细胞、H-1299细胞、HGBEC细胞
HONE1细胞类似产品::T2 (174 x CEM.T2)细胞、TR-146细胞、Rin-M-5F细胞
NCI-H1155细胞类似产品::H-146细胞、MDCK-II细胞、RSMC细胞
SW 1417细胞类似产品::OB2细胞、SKMEL1细胞、U-2 OS细胞
CA-46细胞类似产品::B-95-8细胞、Daoy细胞、9L细胞
P 815细胞类似产品::SPCA1细胞、SNU354细胞、EU-3细胞
H-2591细胞类似产品::HTori-3细胞、A549细胞、CCRF CEM细胞
EU-4细胞类似产品::FUOV1细胞、ZYM-DIEC02细胞、HEK-293F细胞
P3HR1细胞类似产品::SNU119细胞、KYSE 450细胞、Clone 166细胞
HCC0366细胞类似产品::MCF/Adr细胞、RN-c细胞、NTC200细胞
Ca9-22细胞类似产品::C643细胞、MV-4-11细胞、NCIH128细胞
MDA-MB-231-GFP细胞类似产品::EJ细胞、LuCL4细胞、BTI-Tn-5B1-4细胞
NCI660细胞类似产品::87 MG细胞、NCI-H23细胞、MV 4;11细胞
Rat Glomerular Endothelial细胞类似产品::NCIH747细胞、JeKo-1细胞、NCI747细胞
C1498细胞类似产品::EB-3细胞、BJA-B1细胞、Mono Mac 1细胞
B4G12细胞类似产品::MUM2B细胞、PCI:SG231细胞、Hs-578Bst细胞
NR8383细胞类似产品::HAPI细胞、WM 451-Lu细胞、HEK293细胞
RSC96细胞类似产品::PG [Human lung carcinoma]细胞、H-322细胞、Y 1细胞
NCIH208细胞类似产品::L6565细胞、Murine Long bone Osteocyte-Y4细胞、M-G63细胞
Hs 766.T细胞类似产品::NCIH838细胞、HPMC细胞、HT 1376.T细胞
E.G7-OVA细胞类似产品::EOC20细胞、CAKI 1细胞、AD-293细胞
HuH7细胞类似产品::CAL-120细胞、MeT 5A细胞、M 1细胞
LU65细胞类似产品::130 T细胞、H2405细胞、SW 1573细胞
KALS-1细胞类似产品::RA 1细胞、SUDHL1细胞、OVCA433细胞
H-2106细胞类似产品::Japanese Tissue Culture-39细胞、SBC-5细胞、C4 I细胞
SH-SY5Y Parental细胞类似产品::KYSE-70细胞、YD38细胞、Calu6细胞
HTori-3.1细胞类似产品::BEL-7405细胞、TEC细胞、P3HR-1细胞
MiaPaca.2细胞类似产品::MGHU1细胞、L-428细胞、MDA-MB-330细胞
Centre Antoine Lacassagne-39细胞类似产品::Mv 1 Lu (NBL-7)细胞、High 5细胞、CD 18细胞
GM-215细胞类似产品::H2286细胞、KP-N-YN细胞、MonoMac 6细胞
HCCLM6细胞类似产品::LM3细胞、639 V细胞、Capan 2细胞
Hs 606细胞类似产品::L132细胞、NCI-H2081细胞、NTERA-2 clone D1细胞
207细胞类似产品::CHOS细胞、Panc-03.27细胞、HEC1-A细胞
HCC941122细胞类似产品::NCI-H1963细胞、Blotchy fibroblast-11细胞、H-1793细胞
Hs737T细胞类似产品::KLN 205细胞、MDAMB468细胞、HA细胞
DAKIKI Clone 1细胞类似产品::A-431细胞、766T细胞、LLC-MK-2细胞
FDCP-1细胞类似产品::M21细胞、HCC1599细胞、GT1-1细胞
HO8910细胞类似产品::HEC-1B细胞、HBZY 1细胞、H-2330细胞
K422细胞类似产品::N2a细胞、DHL-8细胞、Chang Cells细胞
PANC1005细胞类似产品::H-2198细胞、N-87细胞、MOLM-16细胞
AML-EOL-1细胞类似产品::HSAS1细胞、FAK+/+细胞、NCI-H2009细胞
MS751细胞类似产品::INS1细胞、EJ 138细胞、HEK-293 c18细胞
NCIH1355细胞类似产品::HMSC细胞、D341细胞、T. T细胞
Hep2细胞类似产品::H-660细胞、hFOB1.19细胞、LICR-LON-HN6-R细胞
H-1373细胞类似产品::HCO细胞、CHP 212细胞、MCFs细胞
CII细胞类似产品::MLFC细胞、bEnd3细胞、HEL92.1.7细胞
NCI-H2291细胞类似产品::NCI-H1299细胞、OCI-LY-19细胞、H1435细胞
U251细胞类似产品::Human Lung Microvascular Endothelial Cell line-5a细胞、H-2444细胞、B16-F10-BL6细胞
CTSC-3细胞类似产品::HFF细胞、Nb2-11细胞、SU-DHL-5细胞
RL95细胞类似产品::MMVECs细胞、P30/0HK细胞、OCI/AML-2细胞
Ontario Cancer Institute-Acute Myeloid Leukemia-4细胞类似产品::Hs 294T细胞、U-118MG细胞、HNE-1细胞
786-O RCC细胞类似产品::SMA 560细胞、Murine Carcinoma-38细胞、VK2/E6E7细胞
alpha TC1-6细胞类似产品::Namalva细胞、H-1688细胞、NCIH2228细胞
HEK293-F细胞类似产品::P3-X63Ag8.653细胞、SKG3A细胞、B4G12细胞
GM0637细胞类似产品::SUM149细胞、TOV112D细胞、Leukemic 1210细胞
Hs852T细胞类似产品::UCLA NPA871细胞、NCI-H1573细胞、KTA-7细胞
VM Cub 1细胞类似产品::INS1E细胞、HLEpiC细胞、22Rv1细胞
IPLB-SF-21-AE细胞类似产品::SKMEL24细胞、SCC154细胞、JC细胞
RCC10 RGB细胞类似产品::HCC1187细胞、HEC-1B细胞、Rat Skin 1细胞
675T细胞类似产品::L-428细胞、VM-CUB-I细胞、FRTL 5细胞
C8-D1A细胞类似产品::MN9D细胞、CCRF CEM细胞、CSQT-2细胞
OCI AML2细胞类似产品::MKN-45细胞、SUNE1细胞、GM00346B细胞
Ca9-22细胞类似产品::C643细胞、MV-4-11细胞、NCIH128细胞
GM00215细胞类似产品::OS-RC-2细胞、NCIH524细胞、OCI AML2细胞
TE6细胞类似产品::MEF细胞、Hs 274.T细胞、DLM8细胞
MeWo细胞类似产品::OCI-Ly3细胞、HBVSMC细胞、OPM-2细胞
R 2 C细胞类似产品::CCD-841-CoTr细胞、MDA-468细胞、HCEC-12细胞
HBVSMC细胞类似产品::CAL-27细胞、Kelly细胞、OCI AML4细胞
CHP-126细胞类似产品::OKT 3细胞、CCC-HIE-2细胞、HOC1细胞
H295细胞类似产品::T173细胞、CMK细胞、KRCY细胞
Dunn LM8细胞类似产品::343MG细胞、Fortner's melanotic melanoma #3细胞、BMSCs(mBMSCs)细胞
AMO-1细胞类似产品::Th17细胞、SSP-25细胞、VP303细胞
D-341 Med细胞类似产品::OVCAR8/ADR细胞、EOC-20细胞、HuCC-T1细胞
H2170细胞类似产品::MBdSMC细胞、IM95细胞、MADB 106细胞
HTh 74细胞类似产品::MDA-MB-415细胞、GM00637细胞、IOSE-Mar细胞
NCIH2023细胞类似产品::CHP 100细胞、COLO 206细胞、Glioma-261细胞
X63-Ag8细胞类似产品::H187细胞、SW 1783细胞、H1930细胞
NCI-H841细胞类似产品::BNL.1ME A.7R.1细胞、NOZAWA细胞、Colo16细胞
C57/B6-L细胞类似产品::Hs611T细胞、CCD-112CoN细胞、P3 88 D1细胞
B5537SKIN细胞类似产品::MLTC-1细胞、HT 29细胞、OVCAR-3细胞
MSB1细胞类似产品::LIPF178C细胞、HGC-27细胞、KPL1细胞
NCI-H1882细胞类似产品::HOPC细胞、SEM细胞、SKCO-1细胞
ME16C细胞类似产品::NCI-H250细胞、CWR22-R1细胞、PC-9细胞
LICR-HN-6细胞类似产品::MB468细胞、KAT-5细胞、NB4细胞
CAL33细胞类似产品::RPMI-1846细胞、SNU-520细胞、NCIH2066细胞
HCC-94细胞类似产品::BC-019细胞、JROECL 33细胞、JVM-2细胞
MDA-kb2细胞类似产品::COLO-699细胞、ketr 3细胞、P3/NS1/1-Ag4-1细胞
MES-SA/Dx-5细胞类似产品::RS1细胞、HEK 293T/17细胞、HSCT6细胞
TCC Sup细胞类似产品::Hs 695.T细胞、OCI-Ly01细胞、OCILY10细胞
U251MG细胞类似产品::3AO细胞、Cattle chondrocytes细胞、MCF10A细胞
DSL6A/C1细胞类似产品::HSC-4细胞、SW 900细胞、LK-2细胞
OLN 93细胞类似产品::Co320细胞、NCI-H2452细胞、Stanford University-Diffuse Histiocytic Lymphoma-16细胞
MRC 5细胞类似产品::BE2-C细胞、PE CA PJ34细胞、RC-4B细胞
N2a细胞类似产品::MPP89细胞、Gejiu Lung Carcinoma-82细胞、SNU16细胞
OVCA 420细胞类似产品::IOSE 80细胞、RT-112细胞、NK92MI细胞
MS751细胞类似产品::INS1细胞、EJ 138细胞、HEK-293 c18细胞
Nb-2细胞类似产品::C666-1细胞、SK MEL 5细胞、CL40细胞
MFE 296细胞类似产品::SK UT 1细胞、RPMI-7666细胞、NCI-SNU-1040细胞
LS513 Cells(赠送Str鉴定报告)|人盲肠癌细胞
ChaGo-K-1细胞类似产品::Michigan Cancer Foundation-7细胞、LS123细胞、CAKI1细胞
AN-3细胞类似产品::U373MG细胞、COLO 320细胞、HCM细胞
Hs819T细胞类似产品::HS-766-T细胞、U2OS细胞、INS1-E细胞
WERI-Rb1细胞类似产品::GCT细胞、Human Intestinal Epithelial Cell-6细胞、CAOV3细胞
NS1-Ag4细胞类似产品::NCI-H2196细胞、OCI-Ly 3细胞、SW-626细胞
MT-2细胞类似产品::Stanford University-Diffuse Histiocytic Lymphoma-16细胞、SKNO-1细胞、RPTEC TERT1细胞
MS 751细胞类似产品::OVCA5细胞、BALB 3T3 clone A31细胞、NCI-H520细胞
4T1细胞类似产品::BSC40细胞、T173细胞、SK_HEP1细胞
OVCAR-4细胞类似产品::WML2细胞、MBT2细胞、H-2591细胞
MDA-468细胞类似产品::HOC-1细胞、SO-Rb 50细胞、TCCPAN2细胞
C38细胞类似产品::SUDHL1细胞、NCI-H441-4细胞、RBL 2H3细胞
OSA细胞类似产品::SHIN3细胞、SUDHL-4细胞、OCI-Ly07细胞
MGH-U1细胞类似产品::OCI-AML2细胞、IM-9细胞、GM02219C细胞
BT483细胞类似产品::SN-12C细胞、RPMI8226/S细胞、NCI-H1648细胞
TOV-112D细胞类似产品::ECGI10细胞、HEK293-H细胞、Hs68细胞
M4e细胞类似产品::GBCSD细胞、JeKo 1细胞、H676B细胞
MLMEC细胞类似产品::U-266细胞、GDM-1细胞、HuT-78细胞
HIT T-15细胞类似产品::CORL23细胞、SGC 7901细胞、SK RC 20细胞
MDA-MB 361细胞类似产品::Roswell Park Memorial Institute 6666细胞、HUASMC细胞、SF-126细胞
KMS11细胞类似产品::B 95-8细胞、HCA-7细胞、RBMEC细胞
hSCC-25细胞类似产品::SF 295细胞、K1735细胞、HDF-a细胞
BEL7405细胞类似产品::GDM1细胞、MD Anderson-Metastatic Breast-361细胞、CAL33细胞
MNNG-HOS (Cl#5)细胞类似产品::P31-FUJ细胞、HCGC细胞、Hi-5细胞
NCI-H1944细胞类似产品::RBL2H3细胞、RA细胞、NCI-H596细胞
P31 FUJ细胞类似产品::MDA-MB453细胞、PAMC82细胞、NT2/D1细胞
Hep 3B2.1-7细胞类似产品::MDAMB134细胞、LAPC4细胞、BT-325细胞
SUM-102PT细胞类似产品::MZCRC1细胞、UWB1289细胞、D283细胞
MDA-MB-175-VII细胞类似产品::SW-1463细胞、KOSC2细胞、NB.4细胞
H-2052细胞类似产品::SUM149-PT细胞、University of Arizona Cell Culture-893细胞、HPAF/CD18细胞
CCRF CEM细胞类似产品::ARO81-1细胞、NS1-Ag4细胞、UPCI-SCC-154细胞
BV-173细胞类似产品::Hs 940.T细胞、WC00044细胞、H2141细胞
AHH1细胞类似产品::RIN-m 14B细胞、H-1792细胞、TCC Sup细胞
"